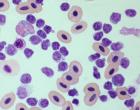
Avian leukocytes in a  blood smear

Drawing blood from a bird is tough, particularly from a wild bird. Wild ducks do not just sit there, stick out a leg, and let you poke them with a needle, happily quack, quacking away. It takes training, patience, and a steady hand to get any wild bird properly handled and positioned for a successful blood draw in the field.
In a collaboration with SUNY-ESF and the DEC, Dr. Krysten Schuler from the CWHL conducted hands-on training in blood collection for an upcoming research project on mallards and black ducks on Long Island. Dr. Mike Schummer and his Master’s student, Aidan Flores were keen to learn the proper blood collection techniques. After a training session on Dr. Schummer’s chickens and guinea fowl, they headed out to Cayuga Lake where the DEC was working on their annual waterfowl banding.
Biologists Jim Eckler, Frank Morlock, and Kent Kowalski were set up along the western shore where a stiff wind was blowing. The thermometer read 12 degrees F, but with the wind chill – it was closer to zero. Aidan practiced collecting blood and spreading it out on glass slides so that the cells could be identified and counted in the lab. Field biologists have to get good at doing high tech work in the back of a pick-up truck!
The following day, Aidan brought his blood slides to the Clinical Pathology lab at the AHDC. Bird blood cells are very different from mammals and have to be counted the old-fashioned way under a microscope rather than by machine. Medical technologist assistant, Megan Rohblee, also a licensed wildlife rehabilitator, was kind enough to demonstrate proper slide staining and helped identify blood cell types. Check out more images of avian blood cells using eClinPath, an online textbook for Veterinary Clinical Pathology.
Dr. Schummer and Aidan next head down to Long Island to get some additional advice from our duck pathologist, Dr. Gavin Hitchener, at the Cornell Duck Lab. We wish them warmer weather!